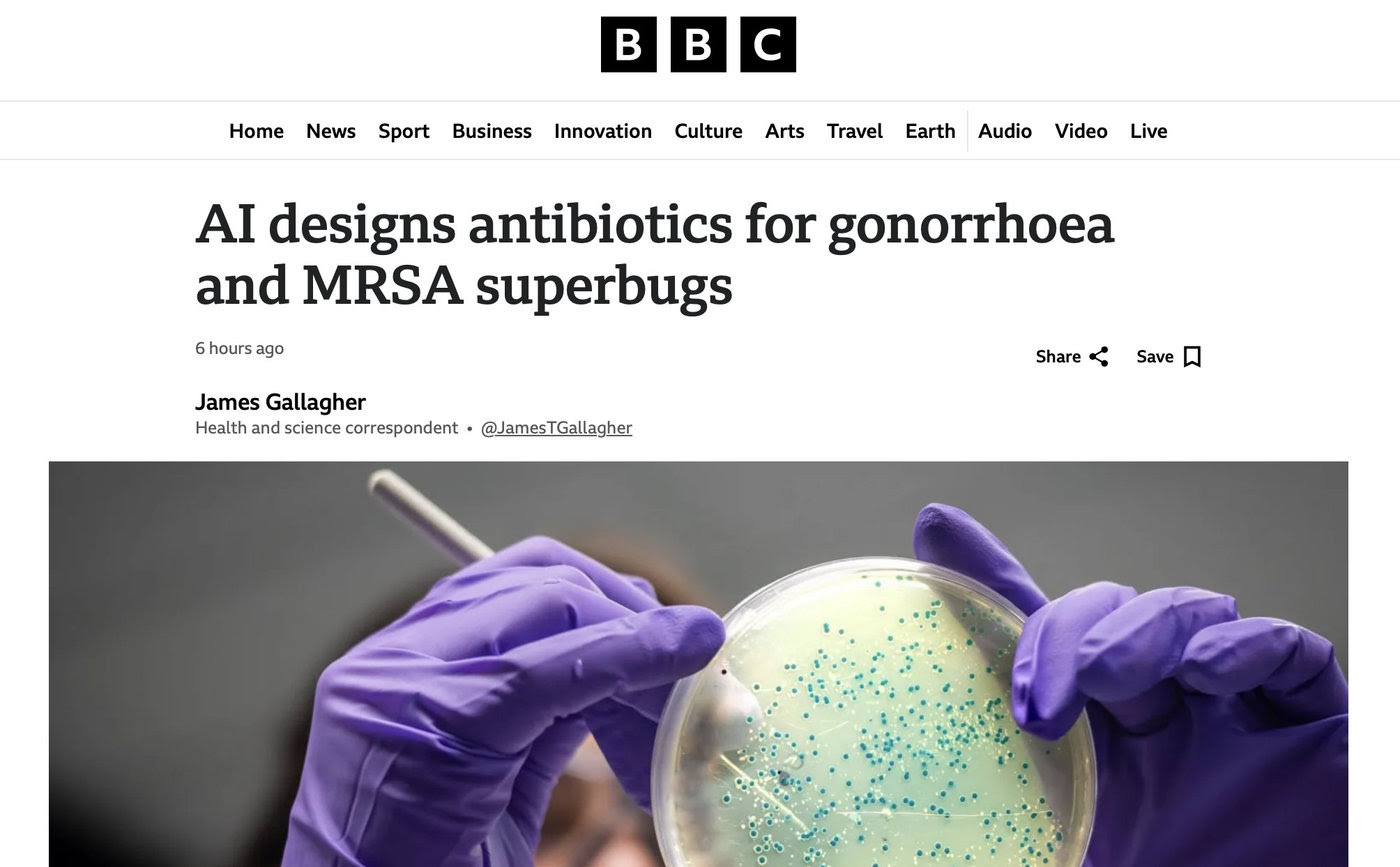
항생제 제2황금기 온다… 생성형 AI가 슈퍼버그 신약 2종 설계

MIT 연구팀 성과… "임균·MRSA에 효과적" 동물실험에서 확인
인공지능(AI)이 설계한 새 항생물질이 동물 실험에서 우수한 효과를 보였다고 영국 BBC 방송이 14일(현지시간) 보도했다.
미국 매사추세츠공대(MIT) 연구팀은 성병인 임질을 일으키는 임균과 메티실린 내성 황색포도상구균(MRSA)에 효과가 있는 새 항생제 후보물질을 생성형 인공지능(AI)을 이용해 개발하고 동물 실험에서 효과를 입증했다는 연구 결과를 과학저널 셀(Cell)에 게재했다.
연구팀은 먼저 기존에 존재하지 않거나 아직 발견되지 않은 물질까지 포함해 3천600만개의 화합물을 조사하는 AI 모델을 만들었다.
연구팀은 이 AI 모델에 기성 화합물들의 화학구조와 함께 이들이 다양한 병원성 세균의 성장을 억제하는지 여부를 학습시켰다.
AI 모델은 이어 탄소, 산소, 수소, 질소 등의 원자로 구성된 다양한 분자구조에 박테리아가 어떻게 영향을 받는지를 학습했다.
연구팀은 이렇게 학습시킨 AI 모델을 기반으로 두 가지 방식으로 새 항생물질을 설계했다. 하나는 8개에서 19개의 원자로 이뤄진 화학물질 수백만 개의 데이터를 검색해 단서를 찾아내고, 이를 출발점으로 신물질을 설계하는 방식이고, 또 다른 하나는 AI에게 처음부터 자유 설계를 맡기는 방식이었다.
이후 연구팀은 AI 모델에 이미 상용화된 항생제와 유사한 물질은 제외하도록 했고, 인체에 유해할 수 있는 화합물도 배제하도록 했다.
이렇게 얻어진 새 화학물질은 실험실 배지에서 병원성 세균의 성장을 억제하는 것이 확인됐다. 이어 쥐를 대상으로 한 동물 실험에서도 우수한 효과를 보였다.
연구팀은 연구 결과가 항생제 개발의 '제2 황금기'를 여는 전환점이 될 것으로 기대했다.
MIT 연구팀의 제임스 콜린스 교수는 "생성형 AI가 완전히 새로운 항생물질을 설계하는 데 이용될 수 있다는 것을 보여줄 수 있어서 기쁘다"면서 슈퍼버그(항생제 내성 슈퍼박테리아)와의 싸움에서 큰 도움이 될 것이라고 말했다.
이번 시험 결과가 임상시험을 거쳐 처방할 수 있는 상용 항생제 개발로 이어지기 위해서는 수년에 걸친 추가 연구와 승인 등 복잡한 절차가 필요하다고 BBC는 전했다.
미국 8월 소비심리 반락… '관세 인플레이션' 우려 확대
8월 미시간대 소비자심리 4개월 만에 악화… 기대 인플레는 반등

도널드 트럼프 미국 대통령의 관세 정책이 물가를 밀어 올릴 것이란 우려가 다시 확대되면서 8월 들어 미국 소비자들의 경제 심리가 악화했다.
미 미시간대는 미국 경기에 대한 소비자들의 자신감을 반영하는 소비자심리지수가 8월(잠정치) 58.6으로 전월 대비 3.1포인트 하락했다고 15일(현지시간) 밝혔다.
소비자심리지수가 전월 대비 하락을 나타낸 것은 지난 4월 이후 4개월 만이다.
6월 대비 소비자 심리가 개선될 것이라고 본 전문가 전망(62.5·다우존스 집계 기준)에도 크게 못 미쳤다.
미시간대 소비자심리지수는 트럼프 행정부의 관세 정책 불확실성 탓에 올해 초 하락 흐름을 지속하다가 5월 보합에 머문 뒤 6∼7월 들어 무역 협상 진전과 증시 랠리에 힘입어 반등한 바 있다.
그러나 관세 부과가 인플레이션 반등으로 이어질 것이란 기대가 다시 커지면서 소비자 심리지수를 다시 끌어내린 것으로 풀이된다.
이날 발표된 보고서에서 미국 소비자들의 향후 1년 기대 인플레이션은 7월 4.5%에서 8월 4.9%로 상승했다.
소비자들의 장기 인플레이션 전망을 반영하는 5년 기대 인플레이션은 7월 3.4%에서 8월 3.9%로 올랐다.
이는 관세에 따른 물가 상승 충격이 일회성에 그치지 않고 장기적으로 영향을 미칠 수 있다는 소비자들의 우려가 반영된 것이다.
미시간대 소비자심리지수 집계를 관장하는 조안 슈 디렉터는 "소비자들은 상호관세 발표가 있었던 지난 4월처럼 최악의 경제 시나리오를 대비하는 모습은 아니다"라면서도 "그러나 소비자들은 인플레이션과 실업률이 향후 악화할 것이라는 기대를 지속하고 있다"라고 말했다.

* 주요 뉴스/사건 브리핑 *
오늘 핵심
소비는 견조: 7월 소매판매 전월 대비 +0.5%, 코어(자동차·가솔린·자재·외식 제외)도 +0.5%. 자동차·온라인이 견인. 다만 고용 둔화가 향후 소비 리스크.
물가 혼조: 7월 CPI +0.2% m/m, +2.7% y/y, 근원 +0.3% m/m(근원 y/y 3.1%). 항공요금·의료가 상승, 에너지는 하락.
도매물가(PPI) 서프라이즈: 7월 PPI +0.9% m/m(3년래 최대). 관세 여파로 재화/서비스 가격 동반 상승.
심리 둔화: 미시간대 8월 예비 소비심리 58.6(전월 61.7→하락). 1년 기대인플레 상승.
지수 동향: 다우, 장중 사상 최고치 터치—버핏의 버크셔가 UnitedHealth(UNH) 신규 지분 공시로 헬스케어 급등. S&P/Nasdaq은 혼조.
정책·정치 재료: 美 정부의 인텔(INE) 지분 투자 검토 보도에 인텔 주가 상승(칩스법 자금 연계 가능성). 반면 반도체·철강 추가 관세 예고 뉴스로 인플레·밸류체인 변동성 확대.
채권·원자재: PPI 급등 이후 국채금리 상승(10Y ~4.29% 근처), 유가 하락(트럼프–푸틴 알래스카 회담 관망, 中지표 둔화).
이번 주/다가올 일정
7월 CPI 상세: 항목별로 주거·의료·항공요금↑, 에너지↓.
소매판매·수입물가: 7월 수입물가 +0.4%로 소비재 중심 상승. 관세 전가 가능성 시사.
FOMC(9/16–17) 앞두고 시장은 9월 25bp 인하 가능성에 무게, 다만 핫한 PPI로 논쟁 심화(일부 기관은 “9월 동결” 전망). 잭슨홀 8/22 파월 발언 주목.
다음 CPI 발표: 9/11(목) 8:30am ET 예정.
섹터/테마 한줄 코멘트
헬스케어: 버핏 매수 효과로 메가캡(보험·관리형케어) 리바운드. 단, 업황(이용률↑, 마진압박) 정상화 시간 필요. 추세 전환 초기 관점.
반도체/하드웨어: 정부 개입·관세 리스크가 동시 존재—단기 뉴스 민감도↑. 인텔 이슈는 펀더멘털 개선과 별개로 변동성 확대 요인.
소비재/리테일: 판촉·자동차는 견고하나 레스토랑·자재/전자 소매는 약화—양극화 소비 지속.
에너지: 유가 약세로 단기 모멘텀 둔화(지정학 관망+中수요 우려).
단기 투자전략 (8월 말~9월 FOMC 전)
퀄리티 바벨:
방어주(헬스케어·필수소비) 비중 소폭 확대(실적 가시성+배당 완충) + 현금흐름 탄탄한 대형 성장주 보유. 뉴스 변동성에 덜 흔들리고 하락 시 매수 여력 확보.
반도체는 ‘뉴스-드리븐’ 트레이딩: 정부지분·관세 헤드라인 따라 베타↑. 포지션은 축소·분할 접근, 실적/로드맵 우위 종목 중심 선별.
금리 민감 자산 관리: 10년물 4.2-4.3%대 등락. 듀레이션은 중립-약간 장기화로 리스크 헤지, 크레딧은 IG 단기채 위주로 스프레드 관리.
소비 테마는 선별: 자동차·이커머스(프로모션 수혜)는 유지, 외식·자재·전자 소매는 비중 보수적.
원자재/에너지: 유가 하락 구간에선 정유·E&P 베타 축소, 대신 운송·화학의 원가완충 모멘텀 탐색.
리스크 체크리스트
관세 확대(반도체·철강 등) → 물가 상방/마진 압박 재부각 가능.
고용 둔화 심화 시 소비 모멘텀 약화, 실적 하향 리스크.
정치 이벤트(알래스카 미·러 회담, 잭슨홀, 9월 FOMC) 헤드라인 변동성.